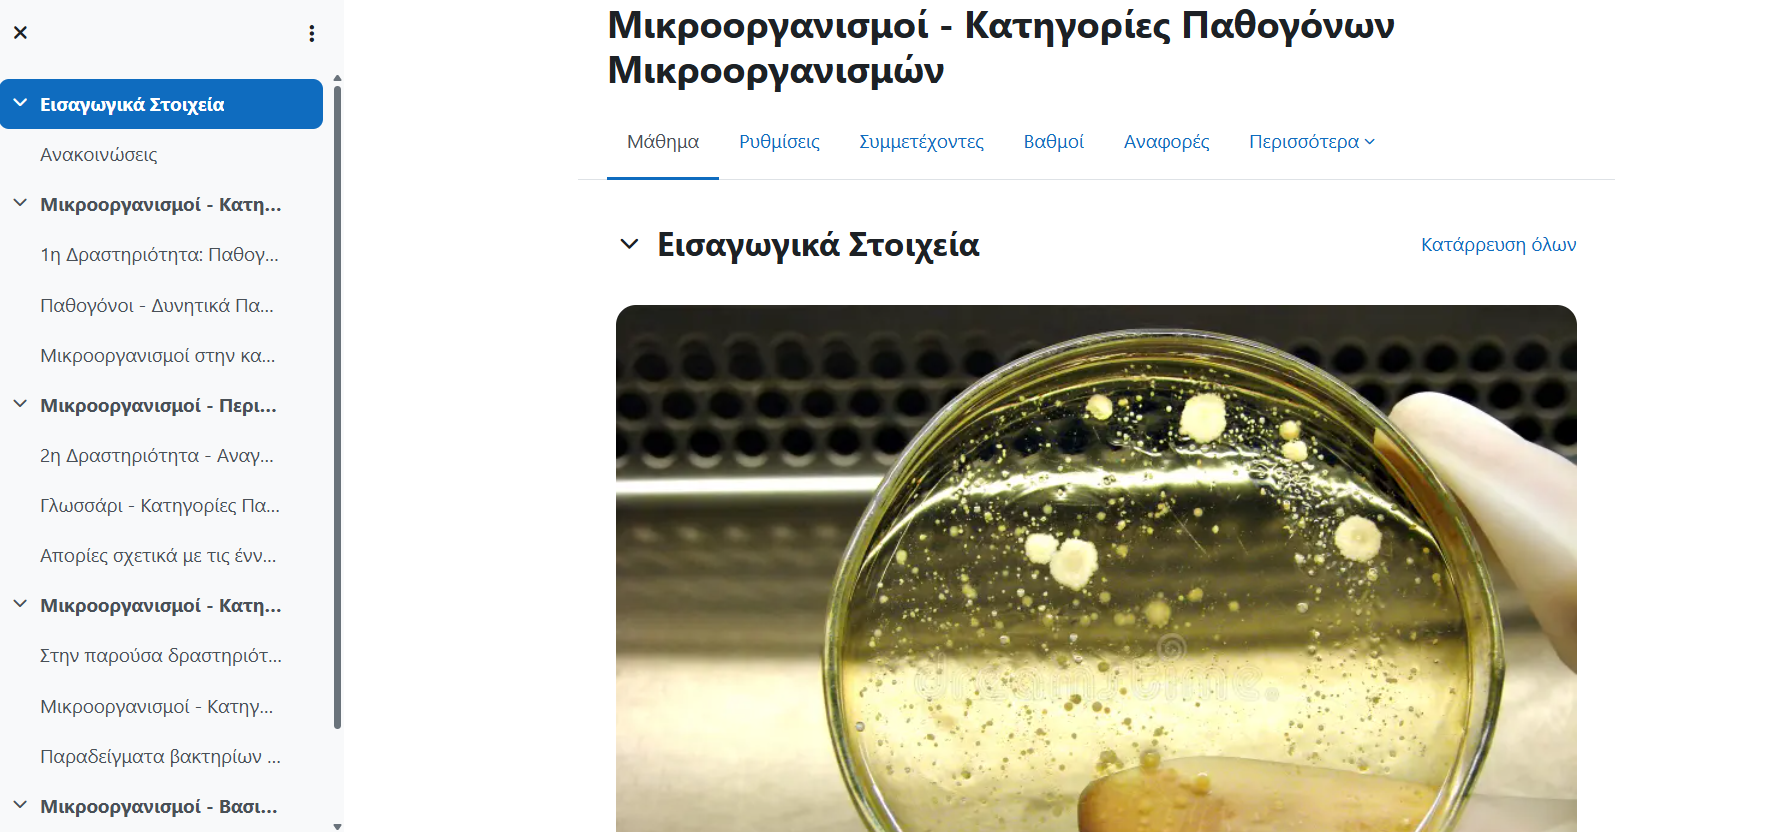

Το Moodle αποτελεί μία ασύγχρονη πλατφόρμα μάθησης την οποία χρησιμοποιήσαμε στα πλαίσια του μαθήματος “Ψηφιακός Μετασχηματισμός – Νέες Τεχνολογίες στη Διδακτική των Βιολογικών Επιστημών”. Κάθε φοιτητής επέλεξε ένα διαφορετικό κεφάλαιο το οποίο και ανέπτυξε στην πλατφόρμα αυτή. Προσωπικά, επέλεξα το κεφάλαιο 1.2 “Μικροοργανισμοί” και 1.2.1 “Κατηγορίες Παθογόνων Μικροοργανισμών” από το σχολικό εγχειρίδιο της Β τάξης Γενικού Λυκείου. Παρακάτω παρατίθενται ο σύνδεσμος της πλατφόρμας και κάποια από τα στιγμιότυπα που δείχνουν τη δουλειά που έγινε στο Moodle.
Σύνδεσμος: https://e-school.biologia.gr/course/view.php?id=188
Εισαγωγικά Στοιχεία


Διαδραστικά Μέσα

Διαδραστική Εικόνα